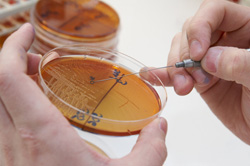

Sondas enzimáticas de quitarse el sombrero
El estudio de qué hace exactamente un gen en términos de producción de proteínas (transcripción genética) está proporcionando muchas moléculas cuya función se desconoce. Entre ellas hay muchas enzimas que controlan la adición de pequeños grupos de átomos a las proteínas recién transcritas. El proyecto financiado por la Unión Europea Dekker40 («Nuevos enfoques para la comprensión de la transcripción de genes utilizando como herramientas pequeñas moléculas») estudió el fenómeno de la modificación postraduccional utilizando inhibidores de pequeñas moléculas. Estos evitan que se produzcan modificaciones, lo que luego permite determinar la función exacta de la enzima en cuestión. Un grupo de moléculas de interés para el equipo son, en concreto, las histona acetiltransferasas (HAT). Se trata de un grupo recién descubierto de enzimas para las que no había inhibidores selectivos que permitieran identificar su función. Los investigadores de Dekker40 estudiaron dos enzimas HAT e identificaron varios inhibidores de ambas moléculas. Este descubrimiento será muy beneficioso a la hora de realizar estudios de perfiles de actividad enzimática en los que los inhibidores se utilizan como sondas en diferentes tejidos para localizar con exactitud las enzimas activas. En los estudios de acetilación de histonas basados en células, los socios de Dekker40 también identificaron inhibidores de las HAT más potentes. Los inhibidores de las HAT basados en el ácido anacárdico, un producto natural que se encuentran en las nueces de anacardo y el mango, produjeron una serie de inhibidores de potencia y selectividad mejoradas. Las enfermedades inflamatorias pulmonares como el asma a menudo se caracterizan por un aumento de la actividad HAT. Los inhibidores a base de ácido anacárdico se presentan como unos candidatos prometedores para el tratamiento de las enfermedades inflamatorias.